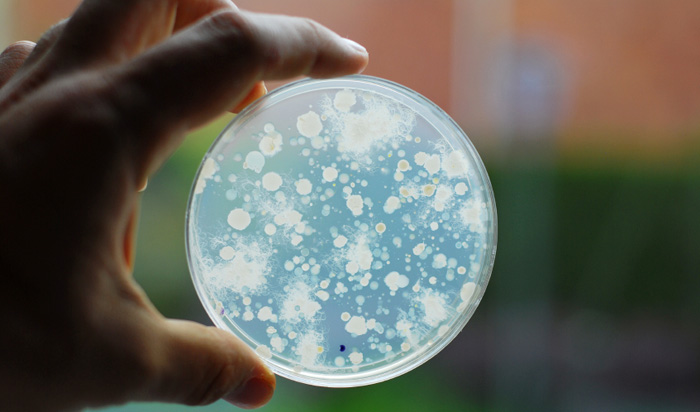

ها هو الفيروس المخيف يعود من جديد ليزرع الرعب في قلوب الناس
#فيروس_كورونا القاتل تسبب بوفاة الالاف من الأشخاص فور ظهوره منذ عدة سنوات، ويعود اليوم للظهور في الصين مع تخوف من انتشاره عالميًا خصوصًا بعد تسجيل بعض حالات الاصابة في كندا والولايات المتحدة.
#فيروس_كورونا القاتل تسبب بوفاة الالاف من الأشخاص فور ظهوره منذ عدة سنوات، ويعود اليوم للظهور في الصين مع تخوف من انتشاره عالميًا خصوصًا بعد تسجيل بعض حالات الاصابة في كندا والولايات المتحدة.
#فيروس_كورونا هو أحد انواع الفيروسات شائعة الانتشار، ويصيب الحيوان والإنسان على حد سواء. وهناك أنواع مختلفة من فيروسات كورونا تتسبب في 15-30% من حالات الرشح
كما أن هناك أنواع معيَّنة تتسبب بحدوث أمراض أكثر خطورة
▪لنتعرف على كيفية الوقاية من فيروس كورونا المميت?
كما أن هناك أنواع معيَّنة تتسبب بحدوث أمراض أكثر خطورة
▪لنتعرف على كيفية الوقاية من فيروس كورونا المميت?
• تجنب الاحتكاك بالأشخاص المرضى بـ #فيروس_كورونا
• تجنب لمس الأنف، والعينين، والفم دون تنظيف اليدين.
▪واقرأ أيضًا.. الصحة الإماراتية تصدر إرشادات توعوية حول #فيروس_كورونا_الجديد : bit.ly
▪واقرأ أيضًا.. الصحة الإماراتية تصدر إرشادات توعوية حول #فيروس_كورونا_الجديد : bit.ly
•غسل اليدين جيدًا بالماء والصابون لتجنب الإصابة بـ #فيروس_كورونا_الجديد خاصة بعد التجول في الأسواق أو المزارع
• استخدام معقم اليدين الكحولي لتنظيفها في حال عدم توافر الماء لغسل اليدين.
▪للمزيد من نصائح للحماية من فيروسات الصيف الخطيرة ومنها #فيروس_كورونا : bit.ly
▪للمزيد من نصائح للحماية من فيروسات الصيف الخطيرة ومنها #فيروس_كورونا : bit.ly
• غسل جميع الأدوات الشخصية المستخدمة من قبل الشخص المصاب بـ #فيروس_كورونا ، بما في ذلك الفراش وأواني الطعام.
• ارتداء الكمامة الطبية في حال التواجد بمكان واحد مع شخص مصاب بـ #فيروس_كورونا .
• التخلص من القفازات في حال لمس أي من سوائل الجسم المصاب بعدوى #فيروس_كورونا
جاري تحميل الاقتراحات...